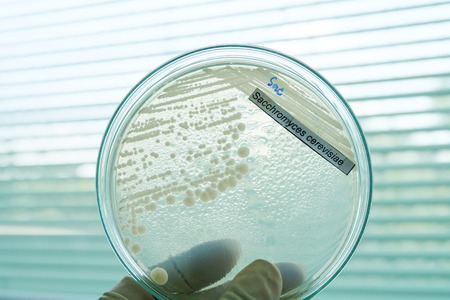
bacteria colony in petridishの写真素材

写真素材 - bacteria colony in petridish
キーワード
- agar
- antibiotic
- bacteria
- bacterial
- biology
- biotechnology
- blue
- chemical
- colony
- culture
- dish
- drug
- education
- experiment
- experimental
- fungi
- grow
- growth
- healthcare
- investigation
- lab
- laboratory
- macro
- medical
- medicine
- microbiology
- microorganisms
- molecular
- organism
- penicillin
- penicillum
- petri
- plate
- research
- science
- slant
- strain
- study
- test tube
- tube
類似作品
petri dish with...
detail of bacte...
microbial cultu...
bacteria colony...
Backgrounds of ...
close-up of col...
bacterial colon...
Different bacte...
Close up view r...
microbial cultu...
Laboratory petr...
petri dish with...
Bacteria in a p...
Microscopic vie...
microbial cultu...
Close up of bac...
Petri dish with...
Colorful variet...
Close up of bac...
Cells that caus...
Backgrounds of ...
Petri dish with...
Bacteria growin...
microbial cultu...
macro of bacter...
Plant Petri on ...
Backgrounds of ...
Colonies of dif...
Macro close up ...
leftover red ca...
Backgrounds of ...
Colorful fluid ...
petri dish with...
Backgrounds of ...
Science and Lif...
Penicillium, as...
Bacteria in a p...
microbial cultu...
Culture in a pe...
Backgrounds of ...
virus cells in ...
Macro close up ...
microbial cultu...
Bacteria and vi...
microbial cultu...
petri dish with...
Backgrounds of ...
Mixed of bacter...
Science and Lif...